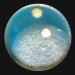
Bild 4

Experimente an der TU Berlin zeigen, wie sich Aerosole und mit ihnen Mikroben sich im Raum ausbreiten.
Bildauswahl:

Experimente an der TU Berlin zeigen, wie sich Aerosole und mit ihnen Mikroben sich im Raum ausbreiten.

Mikroben sind die kleinsten Lebewesen, aber sie haben eine riesige Wirkung.

Biotechnologie der Zukunft: Aus Abwasser können Bakterien Strom produzieren.
Kleinste Mikroben spielen in der Natur und der Geschichte der Menschen eine riesige Rolle.

In der Ostsee suchen Forscher des GEOMAR Kiel nach neuen Antibiotika.
Themen
Details
Mikroben entfalten in der Geschichte riesige Wirkung. Sie sind der Ursprung allen Lebens und nützlich als unsichtbare Helfer. Doch als Krankheitserreger bedrohen sie unser Überleben. Mikroben erfüllen wichtige Aufgaben in Ökosystemen und bestimmen, wie wir Menschen uns ernähren. Einige von ihnen haben jedoch das Potenzial, unsere Zivilisation um Jahrhunderte zurückzuwerfen. Die moderne Medizin wird zum Wettlauf zwischen Mensch und Mikrobe. Die stille Kraft der Mikroorganismen zieht sich wie ein roter Faden durch die Zeitalter. Am Bodensee lassen Forscher die alten Techniken des Bierbrauens mithilfe von Hefe aufleben und geben Einblicke in die Bedeutung der Hefe am Beginn unserer Kulturgeschichte. Früh werden die Menschen jedoch auch von schädlichen Mikroben heimgesucht. Epidemien erschüttern ganze Gesellschaften. Venedig, die majestätische Lagunenstadt, steht lange Zeit vor riesigen Herausforderungen durch wiederholte Pestausbrüche und setzt innovative Methoden ein, um sich zu schützen. Noch heute zeugen Quarantäneinseln vom Alltag während der Pest. Ein dunkler Schatten liegt auch über der Geschichte Südamerikas, als eingeschleppte Krankheitserreger die Ureinwohner dezimieren und die europäische Expansion begünstigen. Im Laufe der Zeit brachten Mikroben auch Hoffnung: Das Antibiotikum, entdeckt im 20. Jahrhundert, revolutioniert die Medizin und rettet bis heute Millionen von Leben. Doch die schädlichen Bakterien holen auf: Durch den massenhaften Einsatz des Medikaments bilden sie Resistenzen. In der Ostsee sucht ein Forscherteam nach rettenden Mitteln. Denn andernfalls könnten lang verschwunden geglaubte Krankheiten zurückkehren. Heute, in einem Zeitalter der Technologie und Innovation, erforschen wir nicht nur neue Impfungen und Medikamente. Möglichkeiten, wie stromerzeugende Bakterien Abwasser in Energie umwandeln können, erinnern uns daran, dass diese kleinen Organismen ein riesiges, ungenutztes Potenzial bergen. Vom ersten Funken des Feuers bis zu den gewaltigen Kräften der Kontinentalverschiebung erzählt die sechsteilige Dokumentationsreihe „Natur macht Geschichte“ von der Wirkung der elementaren Naturkräfte auf die Geschicke der Menschheit. Forschende aus verschiedenen Disziplinen enthüllen überraschende Zusammenhänge von Winden, die Völker verbinden, bis zu Bakterien, die Imperien stürzen.
Hinweis